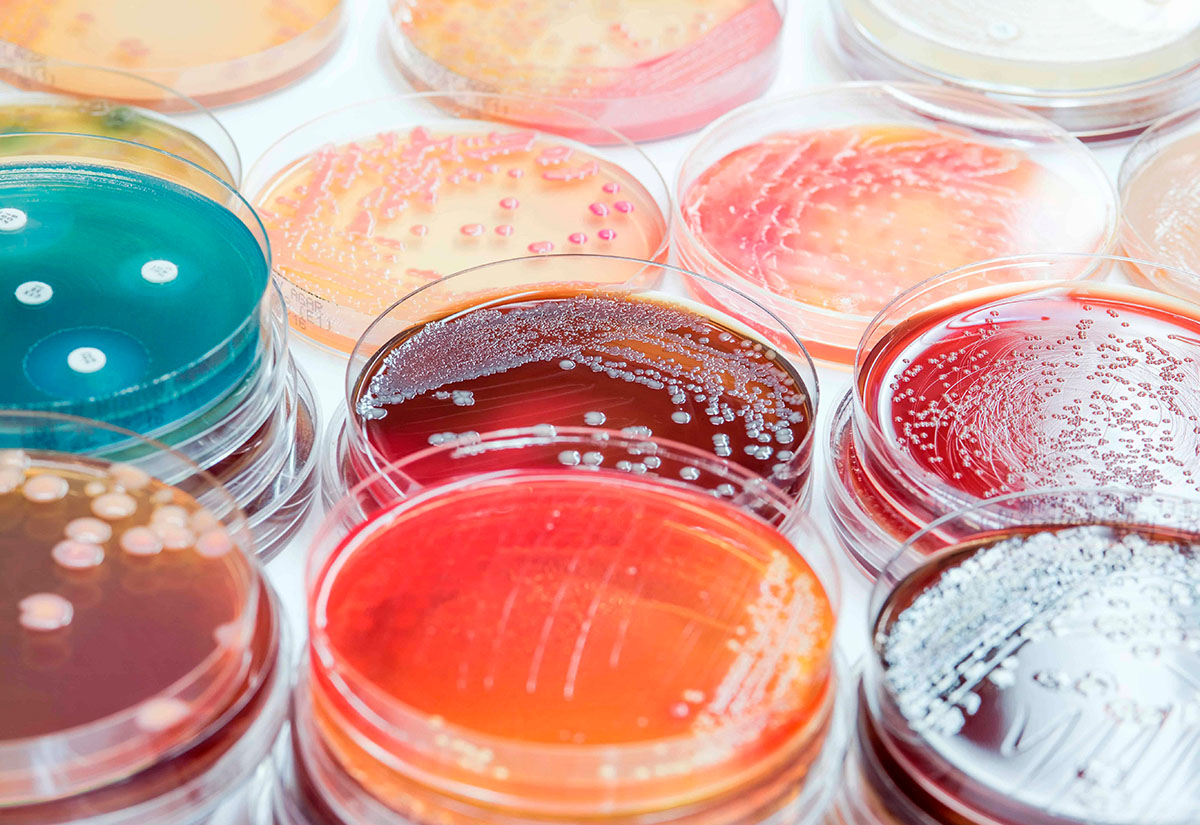

![]()
As competências das áreas de Recursos Genéticos do Instituto Nacional de Investigação Agrária e Veterinária, I.P. (INIAV) integram-se na Unidade Estratégica de Investigação e Serviços de Biotecnologia e Recursos Genéticos (UEIS-BRG).
ATIVIDADES DE INVESTIGAÇÃO & INOVAÇÃO (I&I)
- Promover a conservação dos recursos genéticos nacionais nas áreas animal e vegetal, através da criação e manutenção de coleções vivas e de bancos nacionais de germoplasma;
- Assegurar a conservação, avaliação, documentação e valorização económica dos recursos genéticos nacionais;
- Realização de estudos que visam melhorar a compreensão das relações das plantas e dos animais com o ambiente, de modo a identificar combinações genéticas, mecanismos e tecnologias de reprodução e estratégias de seleção/conservação que explorem, de forma mais eficiente, os recursos naturais disponíveis, particularmente nas regiões mediterrânicas e ainda que contribuam para melhorar a compreensão do seu comportamento face a cenários de possíveis alterações climáticas;
- Desenvolver programas de melhoramento genético de espécies animais e vegetais estratégicas para o desenvolvimento dos sistemas agrícolas, através da introdução de novas variedades e da seleção de raças dessas espécies.